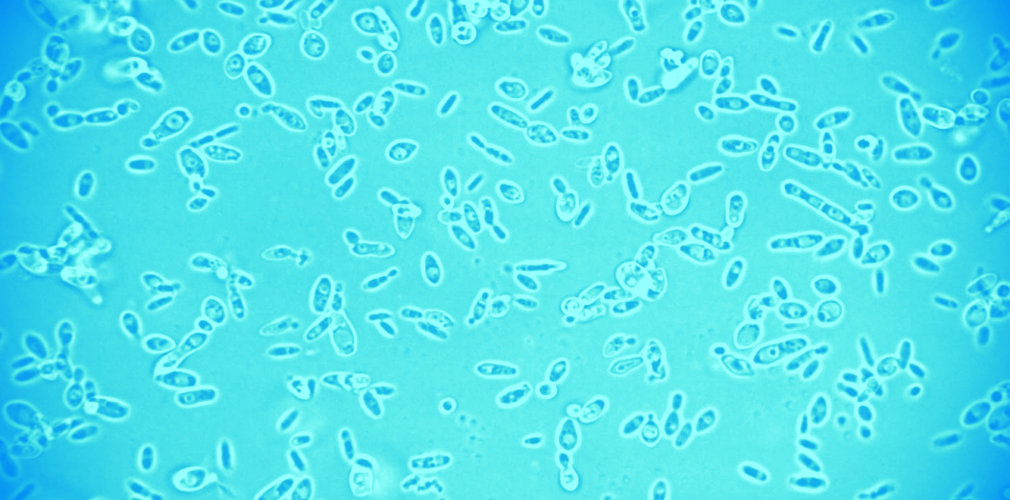

Q:
What is widely considered a serious wine flaw, but conversely a trait that some people want to love, marry and make 10,000 babies with?
A: Brettanomyces!
BrettanoWHUT? Bret-tan-oh-MY-sieze.
It’s quite the peculiar character, that Brettanomyces (or “Brett” as it is affectionately known). Brett is a genus of yeast and a wild one at that. As we all know, or can maybe halfway recall, yeast is a crucial part of winemaking. Brett can exist in the wild on the skins of fruit, but it thoroughly relishes life inside a winery, particularly in oak barrels. Conditions that lead to a higher proliferation of Brett are usually a warmer-than-average winery temperature, older oak barrels and low use of sulfur.
When any kind of yeast feeds on the sugars found in grapes, they convert it into alcohol. So what makes Brett different than other kinds of yeast? And why do some love and some loathe it?
It is thought that Brett typically comes out to party during the window of time between primary and secondary fermentation, when wine is racked (aka: moved) into barrel. It’s slower to develop and doesn’t care to compete with other yeasts that have gotten the alcohol-making started. Unlike cultivated yeasts that are designed to be as neutral as possible, when Brett develops it creates very specific (and wild) aromas in the resulting wine. The most common are:
- A barnyard
- A sweaty leather saddle
- Bacon
- Smoke
- Spices, such as clove or cardamom
- Horse or cow poop (do they smell different?)
- Band-aids
- Antiseptic
- Dirty socks
Some of these things sound quite delicious, no? Who doesn’t love a smokey, spicy red alongside a fat char-grilled burger? But the bandaids, most would agree… not so much. It is a fine line to dance, if a winemaker is to encourage Brett.
Some wine regions are known for their distinct Bretty profiles and have built a following on it. Interestingly, Brett has several different strains of its own which each lead to a unique set of the aromas listed above. But with Brett, being kind of volatile and moody, it’s not always possible to get just the good ones. You may run the risk of ending up with some bandaid with your delicious smokey, bacony red.
The other fascinating thing about Brett is that it is highly dependent on the individual that is smelling it. You may stick your nose in a Côtes-du-Rhone and think “ahhh, there’s that funky barnyard I was craving!” Yet, your companion may be so put off by that same aroma that they immediately start making fun of you on social media.
People’s recognition thresholds are completely different when it comes to these compounds. Once they are detected, some will love and some may loathe. There’s room for all kinds of wine appreciation in the world, but are you born to be wild?